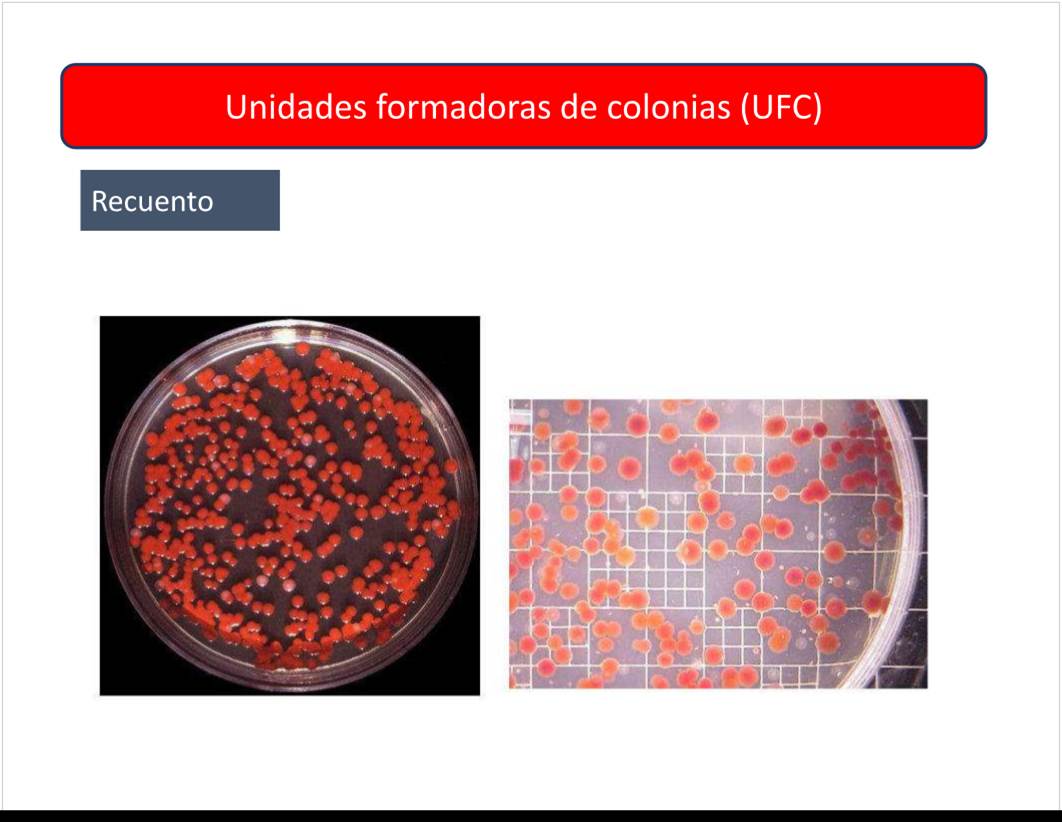

Programa
Wednesday, August 10, 2022
6:45 PM
<<2022_08_08_105900-5849__3_3_100__HIGIENE__SEGURIDAD_Y_MEDIO_AMBIENTE__Belmaa__Maria_Lorena.docx.docx>>


Clases
sábado, 8 de marzo de 2025
23:04
U2 - Tecnica de investigacion
Tuesday, August 30, 2022
10:36 PM
<<Unidad
2 Técnica de investigación.pptx>>




















































U3 - Medicina del trabajo
Tuesday, August 30, 2022
10:40 PM
<<Unidad
3 Medicina del trabajo.pptx>>






























U3 - Actividad Unidades 1 y 2
Tuesday, August 30, 2022
10:41 PM
<<Actividad
Unidad 1 y 2.pptx>>

U4 - Riesgos
Sunday, September 18, 2022
12:43 AM
<<Unidad
4 Riesgos quimicos, fisicos y biologicos.pptx>>




























































U5.1 - Ruido y Vibracion
Wednesday, September 28, 2022
5:51 PM
<<Unidad
5 1 Ruido y vibracion_compressed.pdf>>


















































































U5.2 - Iluminacion
Wednesday, October 5, 2022
11:02 AM
<<Iluminacion_compressed.pdf>>














































U5.3 - Carga Termica
Wednesday, September 28, 2022
5:55 PM
<<Unidad
5 3 Carga termica.pptx>>


























































U5.4 - Radiaciones
Wednesday, September 28, 2022
5:56 PM
<<Unidad
5 4 Radiaciones.pptx>>



























































































U5.5 - Agua Potable
Wednesday, September 28, 2022
5:57 PM
<<Unidad
5 5 Agua potable_compressed.pdf>>

U6 - Ergonomia
Wednesday, September 28, 2022
5:49 PM
<<Unidad
6 Ergonomía.pptx>>













































U7 - Incendios
Wednesday, November 9, 2022
5:30 PM
<<Unidad
7 Proteccion contra incendios.pptx>>































































U8 - Gestion
Wednesday, November 9, 2022
5:32 PM
<<Gestión
ambiental y de seguridad laboral.pptx>>


















































U9 - Medio Ambiente
Wednesday, November 9, 2022
5:32 PM
<<Unidad
9 Introduccion al medio ambiente.pptx>>
































Parcial Tips
Wednesday, September 28, 2022
7:58 PM


Anexos 1P
Monday, October 3, 2022
6:08 PM
|
Unidades |
Tema |
Archivo |
|
Riesgos del trabajo |
<<Resolución 37.docx>> |
|
Ergonomía y levantamiento manual de cargas, y sobre radiaciones |
<<Resolucion 295.docx>> <<Resolución 295.pdf>> |
|
SGA/GHS |
<<Resolución 801.docx>> |
|
|
<<Resolucion 886.docx>> |
|
|
<<Resolucion 900 SRT.docx>> |
|
|
<<Resolución 3345.docx>> |
|
|
<<Ley 24.557 RIESGOS DEL TRABAJO Indice.docx>> <<Ley 24.557 RIESGOS DEL TRABAJO.docx>> |
|
|
<<Ley 26.773.docx>> |
|
|
<<Ley 19587.docx>> |
|
|
<<Decreto 1338.docx>> |
|
|
<<Decreto 911 Construccion.docx>> |
|
|
<<Decreto 658.docx>> |
|
|
<<Decreto 617 Agraria.docx>> |
|
|
<<Decreto 351.docx>> |
|
|
<<Decreto 249 Mineria.docx>> |
|
|
<<Decreto 170.docx>> |
|
|
<<Decreto 49.docx>> |
|
|
<<Anexo 8 Informe anual estadistico.docx>> |
|
|
<<Anexo 7 Proteccion contra incendios.docx>> |
|
|
<<Anexo 5 Acustica.docx>> |
|
|
|
<<Anexo 4 Iluminación y Color.docx>> |
|
|
|
<<Anexo 2 Estres termico.docx>> |
|
|
|
<<Anexo 1 Indice.docx>> <<Anexo 1.docx>> |
Ejercicios Practicos
Tuesday, October 4, 2022
11:43 PM








Picture on page "U5.2 - Iluminacion"
<<Calculo de iluminacion Metodo-cuadricula-HyST.pdf>>
Picture on page "U5.3 - Carga Termica"
Parcial 2021
Wednesday, October 5, 2022
1:19 PM
1. Defina que es un accidente de trabajo para la Ley 24557/95. (1)
2. Indique 5 obligaciones del empleador y 2 obligaciones de los trabajadores (1)
3. En función de qué parámetros se establece la cantidad de horas mensuales que una empresa debe disponer como mínimo de un Servicio de Higiene y Seguridad en el Trabajo (2)
4. Indique cuales son los Objetivos de la Ley de Riesgos del Trabajo 24557/95. ¿Cuáles son los actores del sistema? (2)
5. Defina que es una enfermedad profesional e indique cuales son los requisitos para atribuir carácter de profesional a una enfermedad profesional. Indique cuales son los distintos tipos de exámenes médicos definidos en la normativa argentina e indique cuales deben ser realizados por el empleador (2)
6. ¿Qué es un agente de riesgo? ¿Cómo se clasifican los agentes de riesgo? ¿Qué significan las siglas CMP, CMP-CPT y Valor Techo? ¿A qué tipo de agentes de riesgo es aplicable? (3)
7. ¿Cuál es nivel sonoro continuo equivalente a partir del cual se establece en la normativa el uso obligatorio de protección auditiva? ¿Qué características debe tener una sordera para ser considerada profesional? (3)
8. ¿En qué momento se debe realizar la investigación de un accidente? ¿Qué información se debe utilizar para desarrollar correctamente el método del árbol de causas? (3)
9. Defina ergonomía e indique sus objetivos. Indique cuáles son los factores de riesgo ergonómico laborales y no laborales (3)
10. ¿Cuáles son los objetivos de la protección contra incendios? ¿Qué clase de fuegos conoce? Indique como se debe utilizar correctamente un extintor (4)
1) Es un accidente de trabajo todo acontecimiento súbito y violento ocurrido por el hecho o en ocasión del trabajo (siempre y cuando el trabajador no hay alterado su trayecto por causas ajenas al trabajo)
2) Empleador:
Empleados:
3) Cantidad de trabajadores y su labor.
4)
Los actores son: la superintendencia de Riesgo del trabajo, las aseguradoras de R.T, empleadores, empleados, comité consultivo permanente y las administradoras de trabajo local.
5) Las enfermedades profesionales son aquellas producidas por causas del lugar de trabajo o el tipo de trabajo. Para que sea una enfermedad profesional debe estar en el Listado de Enfermedades Profesionales aprobado por normativa en el cual se identifica el agente de riesgo, enfermedad, exposición, y la actividad, estos son los requisitos para atribuir carácter profesional
Los exámenes médicos son: el preocupacional (pedido por el empleador), examen periódico), los previos a una transferencia de actividad (pedido por el empleador), posteriores a una ausencia y previos a la terminación de la relación.
6) Los agentes de riesgo pueden ser químicos, físicos, biológicos y termo – higrométricos y otros.
CMP: concentración máxima permitida
CMP-CPT: CMP para cortos periodos de tiempo
Valor Techo: es la concentración que no debe sobrepasarse en ningún momento de la jornada laboral del empleado
7) Los trabajadores no pueden estar expuestos a un nivel superior a 85-90 Db, desde este punto deben usar protección obligatoria. Para ser profesional debe ser una hipoacusia perceptiva
8) Luego de un accidente se debe realizar la investigación lo más temprano posible, en el lugar del accidente y por una persona capacitada con el conocimiento del trabajo y su forma habitual de ejecución. Para desarrollar el método del árbol causas se debe partir del suceso ultimo y delimitar sus antecedentes inmediatos con el propósito de poner en evidencia los hechos que contribuyeron a la generación del accidente.
9) Es una ciencia que trata de adecuar las interacciones entre persona y su ambiente/puesto de trabajo. Objetivos: Mejorar la seguridad y el ambiente físico en el trabajo, disminuir la carga física y nerviosa, reducir el trabajo repetitivo, equilibrio entre el hombre y su entorno, etc. Los factores de riesgo laborales: posición, fuerza, frecuencia, iluminación y calor, ruido y vibraciones y carga térmica.
Factores de riesgo no laborales: fisiológico (edad, sexo, etc.), patológicos (secuelas, diabetes, obesidad, etc.), Psicológicos (rasgos de personalidad y sus alteraciones) y sociales (modo de vida, deportes, tabaquismo, café, alcohol, etc.)
10) La protección contra incendios es poder, mediante medidas y/o acciones, limitar las pérdidas materiales debidas a incendio y a minimizar o evitar pérdidas humanas. Los objetivos son dificultar la iniciación de incendios, evitar su propagación y los efectos de gases tóxicos, asegurar la evacuación de personas, facilitar acceso y tareas de extinción al personal de bomberos y proveer las instalaciones de detección y extinción.
Las clases de fuegos son:
Para poder extinguir el fuego se debe utilizar un extintor. Básicamente cuando sucede se debe descolgar y transportar el extintor hacia donde está el fuego. Retirar el precinto y la traba de seguridad direccionando la tobera al fuego que se quiere apagar. Mover la tobera en forma de abanico hacia el fuego.
Parcial Tips 2
Wednesday, November 2, 2022
8:33 PM
Libro purpura
SGA
Temas
TP Final
Tuesday, November 15, 2022
1:03 AM
<<TP
Seguridad, Higiene y MA.pdf>>




















